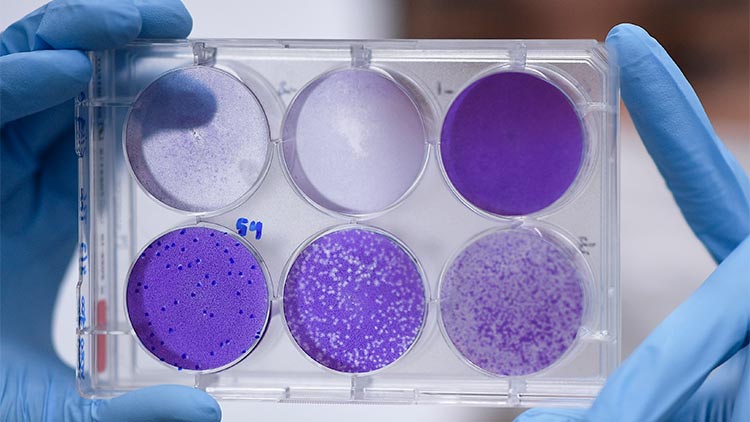

കോവിഡ് 19: പ്രതിരോധ മരുന്ന് എന്നു മുതൽ?
text_fieldsലണ്ടൻ: കർശന നടപടികളുമായി ഭരണകൂടങ്ങൾ കിണഞ്ഞു ശ്രമിച്ചിട്ടും കൊറോണ വൈറസ് വ്യാപനം തടയുന്നതിൽ ദയനീയമായി പരാജയപ്പെടുന്നതിനിടെ പ്രതിരോധ മരുന്ന് എന്നുമുതൽ ലഭ്യമാകുമെന്ന ചോദ്യത്തിന് പ്രസക്തിയേറുന്നു. 40ഓളം കമ്പനികളാണ് നിലവിൽ പ്രതിരോധ മരുന്ന് വികസിപ്പിക്കുന്നതിൽ സജീവമായി രംഗത്തുള്ളത്. ഇതിൽ നാലെണ്ണം ജന്തുക്കളിൽ പരീക്ഷിച്ചു തുടങ്ങിയതായി റിപ്പോർട്ടുകൾ പറയുന്നു. യു.എസിലെ ബോസ്റ്റൺ ആസ്ഥാനമായ മോഡേണ കമ്പനി നിർമിച്ച മരുന്ന് വൈകാതെ മനുഷ്യരിൽ പരീക്ഷിച്ചുതുടങ്ങുമെന്നതാണ് ഏറെ പ്രതീക്ഷ നൽകുന്നത്. എന്നാൽ, ഇവ പോലും ഒരു വർഷം മുതൽ ഒന്നര വർഷം വരെ കഴിഞ്ഞേ വിപണിയിലെത്തൂ.
കോവിഡ്-19െൻറ കാരണക്കാരായ സാഴ്സ്-കോവ്-2 വൈറസിെൻറ ജനിതക ഘടന വേർതിരിക്കുന്നതിൽ ചൈന നടത്തിയ മുന്നേറ്റങ്ങളാണ് മരുന്ന് നിർമാണത്തിനും അതിവേഗം നൽകിയത്. ജനുവരി തുടക്കത്തിൽതന്നെ ചൈന വൈറസിെൻറ ജനിതക ഘടന തിരിച്ചറിഞ്ഞതോടെ ലബോറട്ടറികളിൽ വൈറസ് വികസിപ്പിക്കാനും മനുഷ്യരിൽ എങ്ങനെ പടർന്നുകയറുന്നുവെന്ന് പഠിക്കാനും സഹായകമായിരുന്നു.
കൊറോണ വൈറസ് കാരണം ഈ നൂറ്റാണ്ടിൽമാത്രം രണ്ട് പ്രധാന പകർച്ചവ്യാധികൾ ലോകത്തെ പിടിച്ചുലച്ചിരുന്നു. 2002-04ൽ സാർസ് വൈറസും 2012ൽ മെർസ് ൈവറസും. ദൂരവ്യാപക വ്യാപനമില്ലാത്തതിനെ തുടർന്ന് പ്രതിരോധ മരുന്ന് രണ്ടിനും വികസിപ്പിച്ചിരുന്നില്ല. നേരത്തെ ആക്രമണം നടത്തിയ വൈറസുകളുടെ 80-90 ശതമാനം ജനിതക ഘടനയും കോവിഡിനു കാരണമായ വൈറസിെൻറതുമായി സാമ്യമുള്ളതാണ്. മരുന്ന് വികസിപ്പിക്കുേമ്പാൾ ഇതു കൂടി സഹായകമാകും.
ഏറെ പരിശോധന വേണമെന്നതാണ് വലിയ വെല്ലുവിളി. വൈറസുകൾ കാണിക്കുന്ന കരുത്ത് അടുത്ത പ്രശ്നമാണ്. അതിനാൽ, മിക്കവാറും വർഷങ്ങൾ കഴിഞ്ഞേ ഇവ വിപണിയിലെത്തിക്കാനാവൂ എന്നും ചില ശാസ്ത്രജ്ഞർ പറയുന്നു. അതിനിടെ, ഒാക്സ്ഫഡ് യൂനിവേഴ്സിറ്റിയും യു.എസ് കമ്പനിയായ ഇനോവിയോ ഫാർമസ്യൂട്ടിക്കലും വികസിപ്പിച്ച രണ്ടു മരുന്നുകൾ ജന്തുക്കളിൽ പരീക്ഷിക്കാൻ ലോകാരോഗ്യ സംഘടന അനുമതി നൽകി. കഴിഞ്ഞ മാസം മനുഷ്യരിൽ ഇവ പരീക്ഷിച്ചിരുന്നു. ഇതിെൻറ ഫലങ്ങൾ അടുത്ത ജൂണോടെ ലഭിക്കുമെന്നാണ് കരുതുന്നത്. അതുകഴിഞ്ഞ് അടുത്ത ഘട്ട പരിശോധനകളും വേണ്ടിവരും.
Don't miss the exclusive news, Stay updated
Subscribe to our Newsletter
By subscribing you agree to our Terms & Conditions.